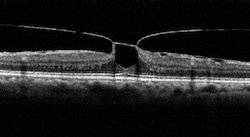

Vitrectomía
Enfermedades Retinales
La vitrectomía es una cirugía que se realiza fundamentalmente por dos motivos: cuando se quiere extraer el humor
vítreo o cuando se quiere acceder a la retina.
En el primer caso se decide extraer el humor vítreo cuando este impide la visión como es al caso de las
hemorragias vítreas comúnmente producidas por enfermedades como la retinopatía diabética o complicaciones de
trombosis venosas retinales. También los traumatismos y los desgarros retinales pueden producir hemorragias en
el humor vítreo.
En el caso que se quiera acceder a la retina debe extraerse primero el humor vítreo. Los motivos por los que se
quiere acceder a la retina son enfermedades retinales que requieren algún tratamiento intraocular.
¿Qué es la Vitrectomía?
La vitrectomía es una cirugía que se realiza normalmente bajo anestesia local y sedación. No se requiere
anestesia general, salvo en niños. Se deben realizar tres incisiones en la esclera para poder acceder
dentro del ojo. Por una de esas vías se coloca una infusión que sirve para mantener el ojo con tono; por
el otro se coloca una fibra óptica que permite ver dentro del ojo y por la otra vía se utilizan
diferentes instrumentos como el vitréctomo que es un instrumento que corta y aspira el humor vítreo.
Además se utilizan pinzas, tijeras, cánulas y otros tantos instrumentos de acuerdo a la necesidad del
caso.
Originalmente para hacer estas incisiones se debía abrir la conjuntiva, hacer tres incisiones de un
tamaño 20 G que al finalizar la cirugía debían ser suturadas, lo mismo que la conjuntiva. Actualmente se
utilizan unos trócares de diámetro 23 a 27G que se insertan a través de la conjuntiva y no requiere la
apertura de la misma. Además estos trócares de menor tamaño se insertan de tal forma que la herida es
valvulada y no requiere de suturas. Todo esto no solo acorta los tiempos de la cirugía sino que hace que
el postoperatorio sea más llevadero y la recuperación del ojo mucho más rápida.
Indicaciones de la vitrectomía
1. Desprendimiento de retina
Los desprendimientos de retina son un claro ejemplo de la necesidad de la vitrectomía. En estos casos se elimina el humor vítreo, se trabaja sobre la retina para eliminar todo tipo de tracciones mediante la extracción de membranas pre o retro retinales, se reaplica la retina utilizando elementos como el perfluorocarbono líquido o el aire, se aplican disparos de láser sobre la retina para lograr una adherencia fuerte entre esta misma y la pared del ojo y de esta manera lograr que la misma quede aplicada e impida que vuelva a desprenderse. Una vez terminado este procedimiento se escoge un sustituto para el humor vítreo que fue eliminado, de acuerdo con la complejidad del caso. Puede utilizarse desde solución fisiológica, aire o distintas mezclas de gases expansivos cuya función es permanecer dentro del ojo más tiempo que el aire (llamados SF6 y C3F8). Una vez que se reabsorben el aire o los gases el ojo mismo reemplaza estas sustancias con un líquido llamado humor acuoso. Este humor acuoso permite la misma calidad de visión que el humor vítreo original. Otras veces, en desprendimientos de retina más complicados debe utilizarse un sustituto del humor vítreo que no se reabsorve como es el aceite de silicón. Este aceite es transparente y permite la visión con corrección óptica adecuada. En algunos casos es necesario retirarlo a los meses pero en otras ocasiones este aceite pueda quedar dentro del ojo de por vida.
2. Proliferación vítreo retinal (PVR)
La PVR es una complicación de cualquier desprendimiento de retina. Es un proceso de cicatrización anormal en el cual se forman membranas celulares contráctiles por delante o por detras de la retina, traccionando sobre ella y generando desprendimientos de retina traccionales con pliegues en la retina.
Factores de riesgo de PVR
- Desprendimiento de retina regmatógeno
- PVR previa
- Desprendimientos coroideos
- Hemorragia vítrea
- Desgarro gigante de retina
- Desgarros en herradura grandes
- Uveítis
Hasta el día de hoy no hay ningun tratamiento farmacológico para prevenir esta complicación. Si se produce
PVR y se desprende la retina es indicación de re operación a la brevedad para recuperar la mejor visión
posible.
El diagnóstico se realiza examinando el fondo de ojo con oftalmoscopio binocular
indirecto o mediante lupas usando la lámpara de hendidura: se observan pliegues fijos en la retina,
general mente inferiores por la gravedad. En casos de falta de visión la ecografía esta indicada y en
casos de desprendimientos muy planos la OCT nos puede mostrar un desprendimiento macular incipiente.
El tratamiento se realiza mediante vitrectomía con extracción de estas membranas que se
pueden ubicar tanto por delante como por detras de la retina. Antiguamente y algunos oftalmólogos hoy en
día combinan la vitrectomía con la colocación de un explante por fuera del ojo y comprimiendo la esclera
para relajar la retina periférica.
Hasta que no se extraen las membranas la retina no puede ser reaplicada. En ocasiones la retina se altera
de tal manera que a pesar de extraer las membranas la retina dquiere una rigidez que no permite ser
distendida; en esos casos se corta la retina, metodo conocido como retinectomía.
Una vez que la retina no tiene más tracciones se la vuelve a adherir a la pred del ojo mediante
perfluorcarbono líquido, aire intraocular o aceite de silicón. Al estar ya adherida se aplica láser sobre
la retina para lograr adhernecias fuertes con la pared del ojo (suelo hacer siempre laser en los 360
grados de la retina para prevenir complicaciones). Finalizado el láser se elige un sustituto del humor
vítreo que en al caso de la PVR serán gases expansibles de larga duración o aceite de silicón dependiendo
de la gravedad del caso, esta decisión es intraquirúrgica.
Luego de esta cirugía de vitrectomía se mantiene el ojo ocluido normalmente hasta el día siguiente en que
el ojo ya queda destapado. Antiguamente se realizaba en el postoperatorio un pocisionamiento boca abajo
por muchos días. Hoy día ya no es necesrio y sólo se le pide a los pacientes evitar dormir boca arriba y
nada mas. Esto es para evitar el contacto permanente de el gas sobre el cristalino que puede generar
catarata y para que cumpla su función de presionar la retina contra la pared del ojo para que esta se
cicatrice. Al día siguiente se le indican gotas antibióticas y antiinflamatorias y el paciente puede
realizar su vida prácticamente normal, evitando deportes por un tiempo prudencial.
3. Retinopatía diabética proliferativa
La retinopatía diabética proliferativa es una complicación de la retinopatía diabética que nunca debería
existir ya que se puede prevenir con tratamiento adecuado. Sin embargo, en muchos casos la falta de
cirulación retinal denominada isquemia, genera la producción de vasos anormales que pueden crecer sobre el
nervio óptico, sobre la retina o en el iris. Estos vasos anormales son los que hacen que un paciente
diabético pierda la visión por dos motivos: porque sangran o porque traccionan y desprenden la retina.
En estas circunstancias es que esta indicada la vitrectomía y cuanto más precoz mejores posibilidades hay
de obtener buenos resultados
4. Agujero macular
5. Pucker macular
6. Tracción vitreo macular
7. Desgarro gigante de retina
8. Desprendimiento de retina y uveítis
Imágenes


Figura 1 a y b. Antiguamente vitrectomía por 20G con suturas de la esclera y apertura conjuntival posteriormente cerrada con puntos.

Figura 2. Vitrectomía transconjuntival a través de trocares 23G, cirugía que se realiza sin suturas.

Figura 3. Proliferación vítreo retinal (PVR) con membranas pre retinales, desprendimiento de retina total y desgarros retinales.

Figura 4. Desgarro gigante de retina.

Figura 5. Desprendimiento de retina por necrosis retinal aguda ya reparado con impactos recientes de laser y aceite de silicón.

Figura 6. Retinopatía diabética con proliferación fibrovascular y hemorragia vítrea inferior.

Figura 7. Agujero macular.

Figura 8. Pucker o plegamiento macular.
Figura 9. Tracción vítreo macular.